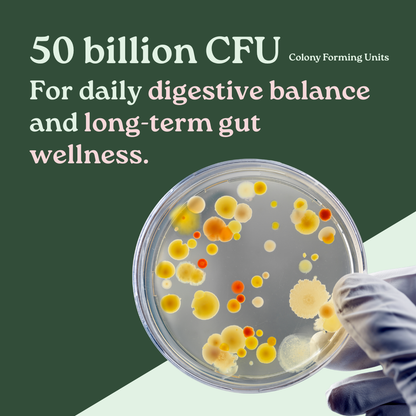
GutBio Probiotic Capsules

Guaranteed to relieve bloating in 60 days or your money back.
What's in the capsule?
Probiotic Blend (50 Billion CFU – 16 Strains)
See Full Strain List above
A powerful mix of healthy bacteria that support your gut, immunity, and feminine balance. These strains are specially chosen for women to:
- Improve digestion and reduce bloating
- Support immune health
- Promote vaginal and urinary health
- Improve digestion and reduce bloating
Organic Maqui Berry Extract (250 mg)
A powerful superfruit from Chile, packed with antioxidants that support healthy aging, fight free radicals, and boost overall vitality.
Cranberry Extract (50 mg)
Cranberries are well-known for helping support urinary tract health and protecting against discomfort or infections.
Vegetable Capsule
We use vegetarian-friendly capsules made from vegetable gelatin, making them easy to take and gentle on your stomach.

What are CFUs?
CFUs (Colony Forming Units) are the measure of the live, active bacteria inside a probiotic supplement. Think of CFUs as the “population count” of beneficial bacteria that are ready to get to work in your gut.
For women, a higher CFU count means more of these good bacteria reach the digestive tract to help rebalance gut flora, break down food, and crowd out the bad bacteria that can trigger discomfort.
This is especially relevant for:
Bloating: When your gut flora is imbalanced, digestion can slow down, leading to trapped gas and a bloated belly. Probiotics with enough CFUs help restore balance so digestion runs more smoothly.
Gentle cleansing: Healthy gut bacteria support regular bowel movements and a natural detox process, helping you feel lighter and less sluggish.
Women’s health: Certain probiotic strains like Lactobacillus rhamnosus and Lactobacillus reuteri support not just gut balance but also vaginal and urinary tract health by maintaining the right pH and reducing the overgrowth of harmful bacteria.
In short, CFUs show you the strength and effectiveness of a probiotic, and for women dealing with bloating, sluggish digestion, or wanting to support overall gut and intimate health, looking for a supplement with the right strains and plenty of CFUs can make a noticeable difference.
Led by Top Scientists and Nutrition Specialists
FAQs
How do I take this supplement?
Take 2 capsules daily with a glass of water. You can take them with or without food, at a time that works best for you.
When will I start to notice results?
Everyone’s body is different, but many women notice improvements in digestive comfort and bloating within 2–3 weeks. For best results, we recommend consistent daily use for at least 3 months.
Can I take this with other supplements or medications?
Our formula is generally safe to use with most vitamins and supplements. If you’re on prescribed medication, we recommend checking with your healthcare provider before starting any new supplement.
Is this supplement safe for long-term use?
Yes. Our probiotics are designed for daily, long-term use. The strains included are clinically studied and safe to take on an ongoing basis.
Are the capsules vegetarian or vegan?
Use collapsible tabs for more detailed information that will help customers make a purchasing decision.
Ex: Shipping and return policies, size guides, and other common questions.
What if I don’t feel a difference?
You’re covered by our 60‑Day Feel‑It Guarantee. Don’t feel a difference by day 60? Email support with your order # for a refund. Guarantees crush risk and lift conversion when clear and specific

